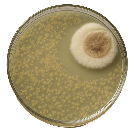
Unha placa como as de Fleming

Glosario
Heterótrofo

-
Definición:
-
Organismo que obtén o seu alimento a partir doutros seres vivos.
-
Exemplo:
-
Os animais herbívoros son heterótrofos.
Serendipia
-
Definición:
-
Descubrimento valioso que ocorre de forma inesperada ou por casualidade, mentres se buscaba outra cousa.
-
Exemplo:
-
Por serendipia, Alexander Fleming descubriu a penicilina ao ver que un fungo impedía o crecemento das bacterias nunha placa de cultivo.
Simbiose

-
Definición:
-
Relación estreita de dependencia entre dous organismos diferentes na que ambos se benefician.
-
Exemplo:
-
Algunhas cianobacterias viven en simbiose con fungos formando os liques.
Quitina

-
Definición:
-
Substancia resistente que forma a parede celular de certos organismos.
-
Exemplo:
-
A parede celular dos fungos está composta por quitina.
 Imos empezar por coñecer este mundo cun contiño "O cogomelo curioso Funghiño".
Imos empezar por coñecer este mundo cun contiño "O cogomelo curioso Funghiño".